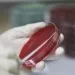

România a intrat sâmbătă după-amiază în scenariul al treilea din lupta împotriva coronavirusului. Asta înseamnă și restricții mai dure față de celelalte scenarii: unul presupune restricționarea adunărilor publice cu mai mult de 50 de persoane.
„Se restricționează activitățile culturale, științifice, artistice, religioase, sportive și de divertisment, care presupun participarea a peste 50 de persoane, realizate în spații închise, inclusiv cele realizate în săli de tratament balnear, săli de fitness, saloane de SPA-uri, de cosmetica, săli de jocuri de noroc și cazinouri”, a transmis Comitetul Național pentru Situații Speciale de Urgență.